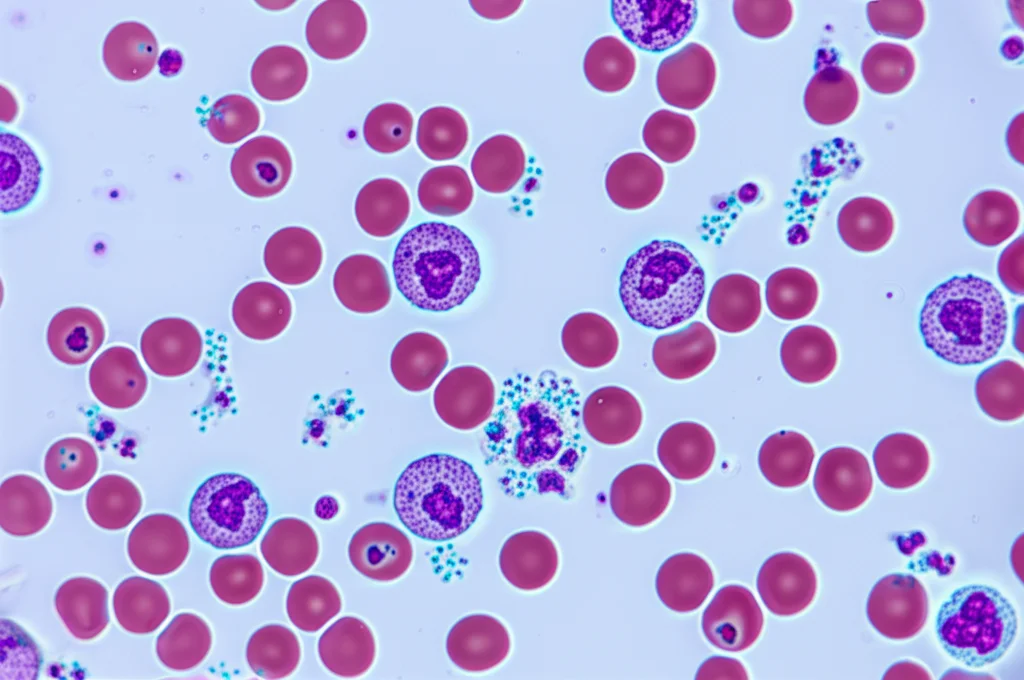
Fotografia macro di un campione di sangue in laboratorio, evidenziando globuli rossi, globuli bianchi (neutrofili visibili) e plasma contenente albumina. Lente macro 100mm, alta definizione, illuminazione controllata da laboratorio, sfondo leggermente sfocato.

NPAR: Il Nuovo Indicatore nel Sangue che Potrebbe Predire il Rischio di Mortalità?
Ragazzi, parliamoci chiaro: nel mondo della medicina, siamo sempre alla ricerca di quella “sfera di cristallo” che ci possa dare qualche indizio sulla nostra salute futura. Non parlo di magia, ovviamente, ma di biomarcatori: segnali nel nostro corpo che possono dirci se siamo più a rischio per certe malattie o condizioni. E ultimamente, un nuovo protagonista si è affacciato sulla scena: il rapporto percentuale neutrofili-albumina, o NPAR per gli amici (e per i ricercatori!).
Forse vi starete chiedendo: “Neutro-che? Albumi-cosa?”. Tranquilli, cerchiamo di capirci qualcosa insieme. I neutrofili sono un tipo di globuli bianchi, i nostri soldatini in prima linea contro infezioni e infiammazioni. Quando il loro numero (o la loro percentuale) sale, spesso è un segnale che c’è un’infiammazione in corso nel corpo, magari cronica e silenziosa. L’albumina, invece, è la proteina più abbondante nel nostro sangue. Pensatela come un indicatore del nostro stato nutrizionale, ma fa molto di più: ha proprietà anti-infiammatorie, antiossidanti e anticoagulanti. Livelli bassi di albumina possono indicare malnutrizione, ma anche un’infiammazione cronica che “consuma” le nostre riserve.
L’idea geniale dietro l’NPAR è combinare questi due valori. In pratica, mettiamo in rapporto la spia dell’infiammazione (neutrofili) con l’indicatore di nutrizione e difesa (albumina). Un NPAR elevato potrebbe quindi suggerire uno squilibrio: troppa infiammazione e/o uno stato nutrizionale non ottimale. E perché questo dovrebbe interessarci? Perché l’infiammazione cronica di basso grado è ormai riconosciuta come un motore subdolo dietro a tantissime malattie croniche, incluse quelle cardiovascolari, che purtroppo restano la prima causa di morte nel mondo.
Lo Studio Gigante: 20 Anni Sotto la Lente
Ora, direte voi, belle parole, ma ci sono prove? Ed è qui che entra in gioco uno studio massiccio, di quelli che fanno davvero drizzare le antenne. Immaginate di seguire per ben 20 anni la bellezza di 36.428 adulti americani, monitorando la loro salute e i loro esami del sangue. È quello che hanno fatto i ricercatori utilizzando i dati del National Health and Nutrition Examination Survey (NHANES), un’indagine super dettagliata sulla salute della popolazione USA, raccolta tra il 1999 e il 2018.
Hanno calcolato l’NPAR per tutti i partecipanti all’inizio dello studio e poi li hanno seguiti fino alla fine del 2019, registrando chi purtroppo non c’era più e per quale causa. I risultati? Beh, piuttosto netti.
Le persone che all’inizio dello studio si trovavano nel terzo più alto dei valori di NPAR (cioè con il rapporto più sfavorevole) avevano un rischio significativamente maggiore di morire per qualsiasi causa rispetto a chi aveva i valori più bassi. Parliamo di un rischio aumentato del 45% (Hazard Ratio 1.45)! E non è finita qui. Se guardiamo specificamente alla mortalità per cause cardiovascolari, il rischio per chi aveva l’NPAR più alto schizzava addirittura al 69% in più (Hazard Ratio 1.69)! Questi numeri sono stati ottenuti tenendo conto di tantissimi altri fattori che potrebbero influenzare la mortalità (età, sesso, fumo, diabete, ipertensione, colesterolo, funzione renale e molto altro), il che rende l’associazione con l’NPAR ancora più robusta.
Non è una Linea Retta: La Complessità della Relazione
Interessante, vero? Ma la storia non è così semplice come “più alto è l’NPAR, peggio è”. I ricercatori hanno usato delle tecniche statistiche un po’ più sofisticate (le “restricted cubic splines”, per i più tecnici) per vedere come cambiava il rischio al variare dell’NPAR. E hanno scoperto una cosa affascinante: la relazione non è lineare, ma assomiglia più a una curva.
C’è un punto, un valore specifico di NPAR (intorno a 13.28 per la mortalità totale e 12.88 per quella cardiovascolare, secondo questo studio), superato il quale il rischio inizia ad impennarsi davvero. Sotto quella soglia, l’associazione tra NPAR e mortalità sembra essere meno marcata o quasi assente. È come se ci fosse un “livello di guardia”: finché stai sotto, tutto ok (o quasi), ma se lo superi, le cose si mettono male più rapidamente.
Questo è stato confermato anche dalle curve di sopravvivenza di Kaplan-Meier: visualizzando graficamente la probabilità di sopravvivenza nel tempo, si vedeva chiaramente che i gruppi con NPAR più alto avevano una curva che scendeva molto più velocemente, indicando una mortalità maggiore e più precoce.
L’Interazione Pericolosa: NPAR e Ipertensione
Un altro aspetto super interessante emerso dallo studio è l’interazione tra NPAR e ipertensione (pressione alta). Sappiamo già che l’ipertensione è un fattore di rischio enorme, specialmente per il cuore. Ma cosa succede quando si combina con un NPAR elevato? Brutte notizie, purtroppo.
Lo studio ha trovato che avere sia un NPAR alto che l’ipertensione aumenta il rischio di mortalità (sia totale che cardiovascolare) molto più di quanto ci si aspetterebbe sommando i rischi dei due fattori presi singolarmente. C’è un effetto quasi “moltiplicatore”, specialmente per la mortalità generale. In termini più semplici: se hai la pressione alta e il tuo NPAR è sballato, il tuo rischio complessivo è particolarmente elevato.
Perché? L’ipertensione stessa è legata a infiammazione cronica e stress ossidativo. Questo può attivare i neutrofili e danneggiare i vasi sanguigni. L’infiammazione, a sua volta, può ridurre la produzione di albumina. Quindi, un NPAR alto in un iperteso potrebbe essere il segnale di un circolo vizioso particolarmente dannoso, dove infiammazione, danno vascolare e forse uno stato nutrizionale compromesso si potenziano a vicenda, accelerando il declino della salute.

Perché Dovrebbe Importarci dell’NPAR?
Ok, abbiamo capito che questo NPAR sembra essere un indicatore importante, ma cosa ce ne facciamo in pratica? Beh, il bello dell’NPAR è che si calcola a partire da due esami del sangue comunissimi ed economici: l’emocromo (che dà la percentuale di neutrofili) e il dosaggio dell’albumina. Non servono test strani o costosi.
Questo lo rende un potenziale biomarcatore ideale: facile da misurare, poco costoso e, come suggerisce questo studio (e altri precedenti su popolazioni specifiche come pazienti con scompenso cardiaco, infarto, cancro, malattie renali), sembra avere un valore predittivo significativo.
Potrebbe diventare uno strumento in più per i medici per stratificare il rischio dei loro pazienti? Per identificare quelle persone che, magari senza sintomi evidenti, covano un’infiammazione cronica o uno stato nutrizionale non ottimale che li mette a maggior rischio a lungo termine? È presto per dirlo con certezza, ma le potenzialità ci sono tutte. Pensateci: un semplice calcolo da esami di routine potrebbe darci un campanello d’allarme prezioso.

Limiti e Prospettive Future
Come ogni studio scientifico, anche questo ha i suoi limiti. Essendo osservazionale, ci dice che c’è un’associazione tra NPAR alto e mortalità, ma non può dimostrare con certezza un rapporto di causa-effetto. L’NPAR alto causa direttamente la morte o è solo un segnale di altri problemi di salute sottostanti che sono la vera causa? Probabilmente entrambe le cose sono vere in parte, ma servono altri studi per capirlo meglio.
Inoltre, i dati provengono dalla popolazione americana non istituzionalizzata, quindi i risultati potrebbero non essere generalizzabili a tutti (ad esempio, a pazienti ospedalizzati). E c’è sempre la possibilità di “confondenti residui”, cioè fattori non misurati che potrebbero influenzare sia l’NPAR che la mortalità.
Nonostante questo, i risultati sono davvero stimolanti. Ci dicono che questo semplice rapporto, NPAR, che combina informazioni sull’infiammazione e sulla nutrizione, merita attenzione. È un candidato promettente come biomarcatore per predire il rischio di mortalità nella popolazione generale.
Cosa ci aspetta ora? Sicuramente servono ulteriori ricerche per confermare questi risultati in altre popolazioni e per capire meglio i meccanismi biologici che legano l’NPAR alla salute a lungo termine. E poi, chissà, magari un giorno il calcolo dell’NPAR diventerà parte della nostra routine di controllo, un piccolo numero in più sul referto che però potrebbe dirci tanto sulla nostra strada verso una vita più lunga e sana. Io, personalmente, terrò d’occhio questo NPAR!
Fonte: Springer







